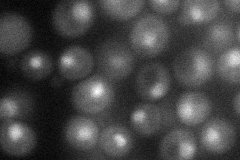
YIL112W
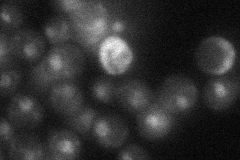
YIL112W
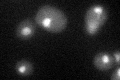
YIL112W

View description
Subunit of the Set3 complex, which is a meiotic-specific repressor of sporulation specific genes that contains deacetylase activity; potential Cdc28p substrate
Localization:
Intensity:
Fold change:
Significance:
-
C’ GFP library in SD

nucleus25.04 -
N' NOP1pr-GFP in SD
cytosol,nucleus41.0212 -
N' TEF2pr-mCherry in SD

nucleus9.44613 -
N' NATIVEpr-GFP in SD
nucleus23.73 -
N' TEF2pr-VC and Cyto-VN in SD

nucleus26.1658 -
C’ GFP library in SD+DTT
nucleus24.310.97No -
C’ GFP library in SD+H2O2

nucleus28.511.13No -
C’ GFP library in Starvation Media

nucleus26.81.07No -
C’ GFP library on the background of Pup2-DaMP

nucleus -
C’ GFP library on the background of CCT mutant

nucleus28.70041.14573No
